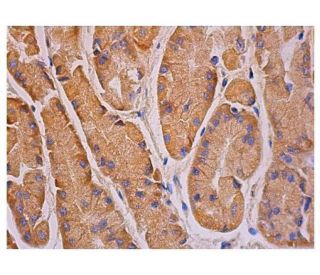
immunohistochemistry image from recommended p-FAK (A-12) monoclonal antibody replacement. Image 348943

Ordering Information
p-FAK (A-12): sc-374668 [ Recommended monoclonal replacement for p-FAK (Ser 722) ]
| Product Name | Catalog # | UNIT | Price | Qty | FAVORITES | |
p-FAK Antibody (A-12) | sc-374668 | 200 µg/ml | $322.00 | |||
p-FAK Antibody (A-12): m-IgG Fc BP-HRP Bundle | sc-527498 | 200 µg Ab; 10 µg BP | $361.00 | |||
p-FAK Antibody (A-12): m-IgG1 BP-HRP Bundle | sc-532871 | 200 µg Ab; 20 µg BP | $361.00 | |||
p-FAK Antibody (A-12) AC | sc-374668 AC | 500 µg/ml, 25% agarose | $424.00 | |||
p-FAK Antibody (A-12) HRP | sc-374668 HRP | 200 µg/ml | $322.00 | |||
p-FAK Antibody (A-12) FITC | sc-374668 FITC | 200 µg/ml | $336.00 | |||
p-FAK Antibody (A-12) PE | sc-374668 PE | 200 µg/ml | $349.00 | |||
p-FAK Antibody (A-12) Alexa Fluor® 488 | sc-374668 AF488 | 200 µg/ml | $364.00 | |||
p-FAK Antibody (A-12) Alexa Fluor® 546 | sc-374668 AF546 | 200 µg/ml | $364.00 | |||
p-FAK Antibody (A-12) Alexa Fluor® 594 | sc-374668 AF594 | 200 µg/ml | $364.00 | |||
p-FAK Antibody (A-12) Alexa Fluor® 647 | sc-374668 AF647 | 200 µg/ml | $364.00 | |||
p-FAK Antibody (A-12) Alexa Fluor® 680 | sc-374668 AF680 | 200 µg/ml | $364.00 | |||
p-FAK Antibody (A-12) Alexa Fluor® 790 | sc-374668 AF790 | 200 µg/ml | $364.00 | |||
p-FAK (A-12) Neutralizing Peptide | sc-374668 P | 100 µg/0.5 ml | $69.00 |